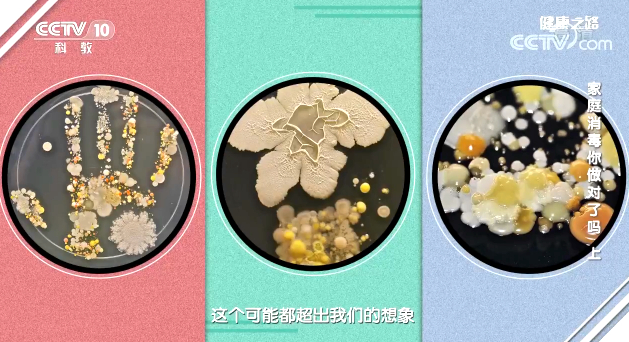

【名醫話健康】家庭衛生你做對了嗎?七步洗手法學習一下
家庭衛生,死角暗藏,居家清潔你做對了嗎?跟著專家一起學習一下。

北京市疾病預防控制中心消毒與有害生物防制所所長佟穎提醒:過度消毒對身體有害,家庭應以清潔為主,只有在一些特定場景或特殊情況下,需要針對物品開展科學、精準地消毒。
開窗通風

流感病毒通過呼吸道進入人體,勤開窗通風有利于新鮮空氣進入室內,稀釋每單位體積內的流感病毒數量,降低感染病毒的幾率,是有效防治流感的方法之一。
戴口罩
如果家里有流感病人,建議病人佩戴一次性醫用外科口罩,以免流感病毒通過飛沫傳染他人。

洗手
由于雙手可能會沾到各種各樣的細菌,正確洗手可以消滅大部分細菌。
乘坐公共交通后、接觸動物后、飯前便后、接觸老人和孩子前、打掃衛生后、打噴嚏后等場景下都要及時洗手。

正確洗手,先記口訣:“內、外、夾、弓、大、立、腕”。

專家提醒:情況允許時,上述七步做完后,盡量選擇流動水洗手15秒。(資料來源:央視《健康之路》)
免責聲明:本文來自寧化在線新聞頻道,不代表寧化在線的觀點和立場。
【責任編輯:馬威】
- 上一篇:全國愛衛辦:強化市場環境整治 降低傳染病通過環境傳播風險[ 06-24 ]
- 下一篇:沒有了!












